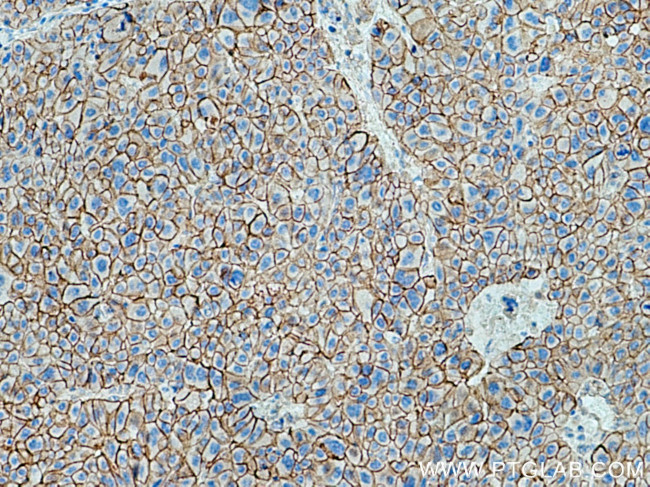
SPTBN1 Antibody in Immunohistochemistry (Paraffin) (IHC (P))

Search
Proteintech
SPTBN1 Polyclonal Antibody
{{$productOrderCtrl.translations['antibody.pdp.commerceCard.promotion.promotions']}}
{{$productOrderCtrl.translations['antibody.pdp.commerceCard.promotion.viewpromo']}}
{{$productOrderCtrl.translations['antibody.pdp.commerceCard.promotion.promocode']}}: {{promo.promoCode}} {{promo.promoTitle}} {{promo.promoDescription}}. {{$productOrderCtrl.translations['antibody.pdp.commerceCard.promotion.learnmore']}}
产品信息
19722-1-AP
种属反应
已发表种属
宿主/亚型
分类
类型
抗原
偶联物
形式
浓度
规格
纯化类型
保存液
内含物
保存条件
运输条件
靶标信息
Spectrin (Sp), the most abundant of the erythrocyte membrane skeleton proteins, helps these cells maintain their characteristic biconcave shape while remaining flexible and elastic. Erythrocyte Sp is a heterodimer composed of a 280 kDa alpha subunit and a 246 kDa beta subunit which associate in a side-to-side, antiparallel configuration to form a 100 nm rod-like structure. Sp in other tissues may be composed of distinct but homologous alpha and beta subunits, sometimes referred to as fodrin. A newly introduced nomenclature designates the Sp subunits of the erythrocyte as alpha-1 and beta-1, and the fodrin subunits as alpha-2 and beta-2. Alternatively spliced forms of each are designated as epsilon-1, epsilon-2, etc. (e. g. beta-1 epsilon-1).
仅用于科研。不用于诊断过程。未经明确授权不得转售。
生物信息学
蛋白别名: beta fodrin; beta-fodrin; beta-G spectrin; Beta-II spectrin; beta-spectrin 2; beta-spectrin 2, non-erythrocytic; beta-spectrin II; beta-spectrin non-erythrocytic 1; brain spectrin; cytoskeleton protein; embryonic liver beta-fodrin; Embryonic liver fodrin; embryonic liver fodrin beta chain; epididymis luminal protein 102; Fodrin beta chain; non-erythrocytic; spectrin beta 2; spectrin beta chain, brain 1; Spectrin beta chain, non-erythrocytic 1; spectrin G; Spectrin, non-erythroid beta chain 1; SPNB2; unnamed protein product
基因别名: 9930031C03Rik; AL033301; betaSpII; DDISBA; ELF; elf1; elf3; HEL102; mKIAA4049; Spnb-2; Spnb2; SPTB2; SPTBN1
UniProt ID: (Human) Q01082, (Mouse) Q62261
Entrez Gene ID: (Human) 6711, (Mouse) 20742